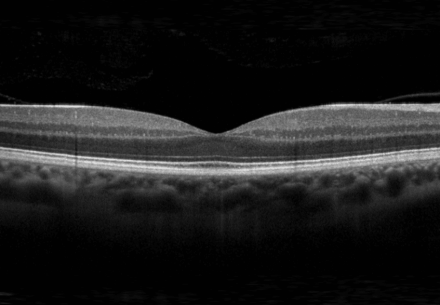
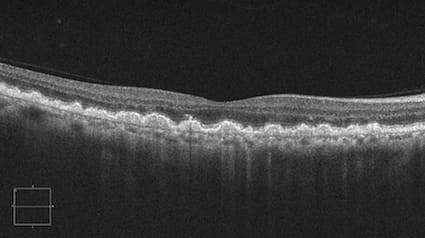
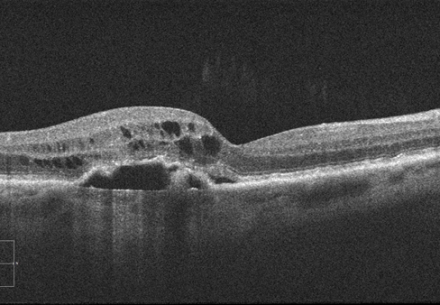

• Trockene AMD: in der Regel alle 6–12 Monate, abhängig vom Befund.
• Feuchte AMD: deutlich enger, meist alle 4–8 Wochen, angepasst an den Krankheitsverlauf und Therapieplan.
• Vorsorge:
• ab 55. Jahren regelmäßige augenärztliche Vorsorge empfohlen
• bei familiärer Belastung (Eltern, Geschwister mit AMD) auch schon früher sinnvoll
So können Risiken früh erkannt und der Verlauf individuell begleitet werden.